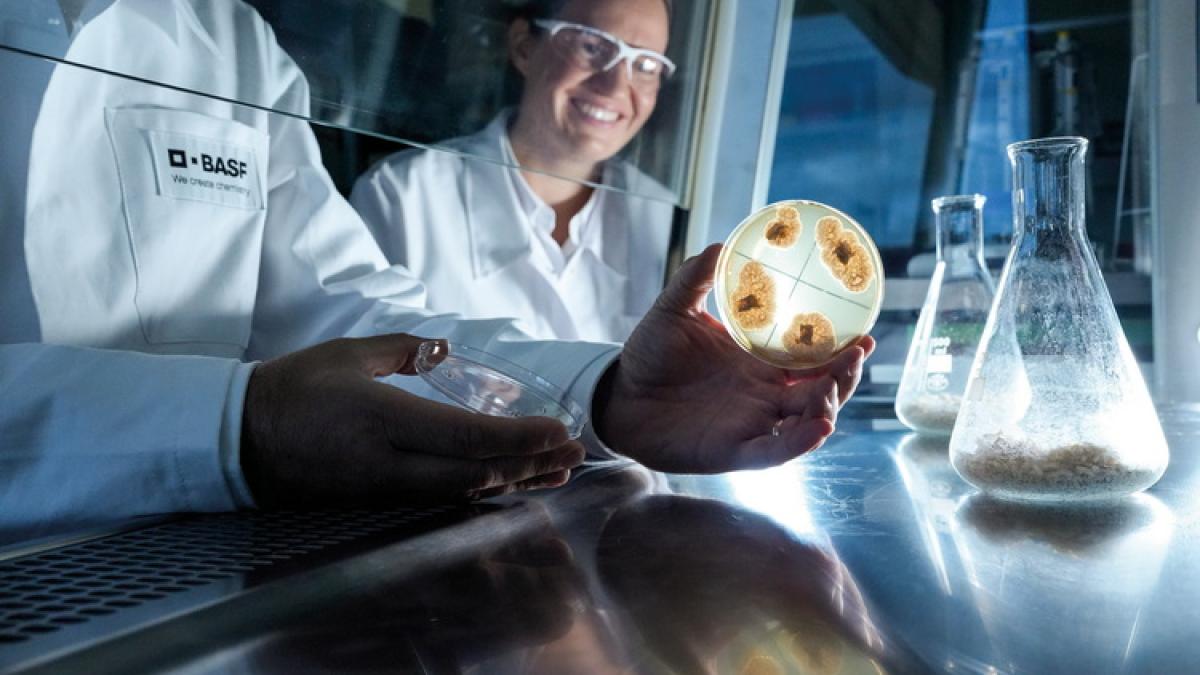
basf_35766600

Cel mai recent exemplu este celebra companie BioNTech, cea care a asigurat tehnologia pentru cele mai performante vaccinuri anti-Covid-19, ser produs în colaborare cu Pfizer. Compania a decis să își mută afacerile în Marea Britanie.
BioNTech, compania admirată la nivel mondial, își mută cercetarea în domeniul cancerului de la Mainz, Germania în Marea Britanie.
Motivul acestei mișcări este birocrația germană șchioapă, scrie Bild. Dezvoltarea medicamentelor este mai rapidă în Anglia, deoarece autoritățile și companiile colaborează îndeaproape, afirmă reprezentanții Biontech. Fondatorul companiei, Özlem Türeci a declarat pentru jurnaliștii germani că: "În cercetare și dezvoltare, BioNTech se bazează pe punctele forte ale țărilor respective. În viitor, va fi esențial să se creeze condiții-cadru contemporane și orientate spre această misiune în diverse domenii."

Özlem Türeci
Acest lucru se aplică "printre altele la finanțarea cercetării și la transpunerea mai rapidă a acesteia în aplicații, la promovarea ecosistemelor biotehnologice în Europa și la reglementările și orientările corespunzătoare", spune Türeci.

Ugur Sahin
Temeri pe termen lung
BioNTech este numai una dintre companiile care pleacă din Germania.
O altă companie din industria farmaceutică germană vrea să facă același lucrul. Este vorba despre gigantul medical Bayer vrea să își relocheze afacerile farmaceutice în China și SUA. Motivul, Europa este "neprietenoasă cu inovarea".
BASF, un mamut al industriei chimice germane, își construiește o nouă fabrică în sudul Chinei, în Zhanjiang (parțial pentru că acolo energia este mai ieftină). Consecința imediată este că la uzina din Ludwigshafen, 39.000 de angajați sunt amenințați cu concedierea.
Motivele migrației invocate de asociațiile de afaceri germane sunt că în Europa există prea multe reglementări (birocrație), costuri prea mari ale energiei, cât și contribuții la asigurările sociale.
Un studiu al "Fundației pentru întreprinderi familiale" arată cât de neatractivă a devenit Germania. Conform acestui studiu, Germania a coborât pe locul 18 în 2022 (din 21 de țări), ceea ce este un lucru dezastruos pentru economia țării.
Banca de stat KfW Bank a avertizat asupra unui nou dezastru: "Temelia pentru o creștere ulterioară a prosperității se prăbușește", potrivit studiului mai sus citat. Deoarece firmele duc lipsă de tot mai mulți muncitori calificați. Până în 2032 cifra ar putea ajunge la până 5 milioane de lucrători.
Economistul șef al KfW, Fritzi Köhler-Geib, avertizează asupra unei "provocări unice". Germania are nevoie, printre altele, de mai multă imigrație și de o educație mai bună.